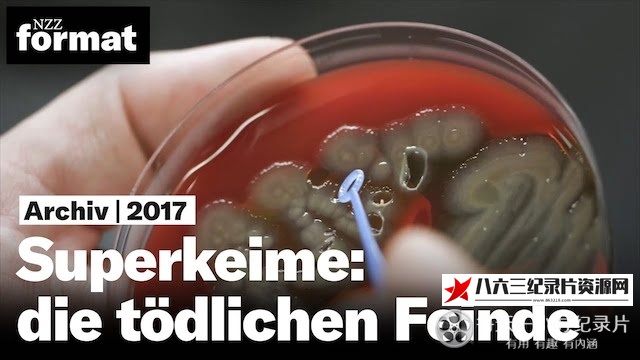
纪录片《有毒的未来 NZZ Format 2017》高清下载-八六三纪录片资源网

超级细菌、海洋垃圾等已经严重危及到地球的环境,人类如果不注重环保,治理环境,终将被自然吞噬,人工智能的出现、科学技术的发展都为人类提供了更多的可能性,人类应该合理利用科技,保护自然环境,让人类生活的环境变得更好。




© 版权声明
文章版权归作者所有,未经允许请勿转载。
THE END
喜欢就支持一下吧
相关推荐
- 美国纪录片《女性救护志愿队 93Queen》高清下载
- 中国大陆纪录片《生活如沸 第二季全8集 Life Is Boiling》高清下载
- 埃及纪录片《阿玛尔 Amal》高清下载
- 中国大陆纪录片《下饭魂·下饭江湖》高清下载
- 美国纪录片《未解之谜 第三季 Unsolved Mysteries Season 3》高清下载
- 中国纪录片《中国 2022 第2季》高清下载
- 美国纪录片《科幻小说中的物理学 Physics.Of.The.Impossible》高清下载
- 英国纪录片《旅行者号:冲出太阳系 Voyager: To the Final Frontier》高清下载
- 美国纪录片《卢旺达的鬼魂 Ghosts of Rwanda》高清下载
- 日本纪录片《和食双神:最后的约定 和食 ふたりの神様 最後の約束》高清下载
- 意大利纪录片《安东尼奥尼:拥有改变电影界的眼睛 Michelangelo Antonioni:The Eye That Changed Cinema》高清下载
- 中国大陆纪录片《胜利大阅兵》高清下载
- 中国大陆纪录片《明月出天山》高清下载
- 美国纪录片《光影留声 电影音乐的故事》高清下载
- 日本纪录片《羽生结弦-24台摄像机记下的自由滑前幕后48小时》高清下载
- 法国,智利纪录片《梦之山脉 La Cordillera de los sueños》高清下载
- 西班牙纪录片《野生链 Wild Connection》高清下载
- 韩国纪录片《人类-动物 휴머니멀》高清下载
- 美国纪录片《重量级闺蜜 全1-3季 1000-lb Best Friends》高清下载
- 中国大陆纪录片《北京味道》高清下载
- 瑞士,美国,法国,德国,澳大利亚,比利时,芬兰,以色列纪录片《和巴什尔跳华尔兹 ואלס עם באשיר》高清下载
- 英国纪录片《西蒙·里夫畅游印度洋 Indian Ocean with Simon Reeve》高清下载
- 中国大陆纪录片《青泥岭》高清下载
- 英国纪录片《英语发展史 The Adventure of English》高清下载
- 英国纪录片《地平线系列:肉食者的困境 Horizon: Should I Eat Meat? The Big Health Dilemma》高清下载
- 美国纪录片《漫威影业:宇宙集结 Marvel Studios: Assembling a Universe》高清下载
- 中国大陆纪录片《莞香传奇 2024》高清下载
- 英国纪录片《波斯 Art of Persia》高清下载
- 中国台湾纪录片《十二夜2:回到第零天》高清下载
- 中国大陆纪录片《财富与梦想:中国股市1990—2010》高清下载
- 中国大陆纪录片《国家自然保护地》高清下载
- 英国纪录片《拉美野生大地 第一季 Wildest Latin America Season 1》高清下载
- 美国纪录片《科学新发现:宇宙之死 Naked Science: Death Of The Universe》高清下载
- 美国纪录片《合众为一 Out of Many, One》高清下载
- 中国大陆纪录片《大三峡》高清下载
- 中国大陆纪录片《动物守护行动 2023》高清下载
- 美国纪录片《彼得、保罗与基督教革命 Empires: Peter & Paul and the Christian Revolution》高清下载
- 英国纪录片《太阳系的海洋 BBC Horizon: Oceans of the Solar System》高清下载
- 美国纪录片《完全可控 Totally Under Control》高清下载
- 美国纪录片《最狂野的梦想:征服珠峰 The Wildest Dream》高清下载
- 美国纪录片《监守自盗 Inside Job》高清下载
- 英国纪录片《俄罗斯艺术 The Art Of Russia》高清下载
- 美国纪录片《与玛丽安娜·范·泽勒一起“贩运” 第三季 Trafficked with Mariana Van Zeller Season 3》高清下载
- 中国大陆纪录片《与全世界做生意》高清下载
- 美国纪录片《传说 Lore》高清下载
- 日本纪录片《行家本色 高仓健特辑 プロフェッショナル 仕事の流儀 高倉健スペシャル》高清下载
- 美国纪录片《超级工厂:特斯拉 Ultimate Factories: Tesla Model S》高清下载
- 英国纪录片《失落的世界 消失的生命 Lost Worlds, Vanished Lives》高清下载
- 美国,埃及纪录片《埃及广场 Al midan》高清下载
- 英国纪录片《北回归线 Tropic Of Cancer》高清下载
- 瑞典,挪威纪录片《伯格曼:人生中的那一年 Bergman — ett år, ett liv》高清下载
- 英国纪录片《行星 The Planets》高清下载
- 英国纪录片《BBC.发明天才 .The.Genius.of.Invention》高清下载
- 中国大陆纪录片《跟着书本去旅行》高清下载
- 中国大陆纪录片《巴扎》高清下载
- 英国纪录片《维多利亚女王和她的子女们 Queen Victoria's Children》高清下载
- 葡萄牙,希腊,Cyprus纪录片《佩索阿遇上卡瓦菲斯的那个夜晚 Τη νύχτα που ο Φερνάντο Πεσσόα συνάντησε τον Κωνσταντίνο Καβάφη》高清下载
- 中国香港纪录片《戏棚 戲棚》高清下载
- 加拿大纪录片《男性末日 The End of Men》高清下载
- 中国大陆纪录片《你所不知道的中国 第一季》高清下载
- 中国大陆纪录片《老广的味道 第四季》高清下载
- 美国纪录片《素食者联盟 The Game Changers》高清下载
- 中国大陆纪录片《考古进行时2017》高清下载
- 英国纪录片《罗斯林大教堂——巨石中的财富 Rosslyn Chapel: A Treasure in Stone》高清下载
- 美国纪录片《马达加斯加:狐猴之岛 Island of Lemurs: Madagascar》高清下载
- 英国纪录片《柏林墙秘史 The Secret Life of the Berlin Wall》高清下载
- 英国纪录片《英国最受欢迎的食物——他们对你有益吗? Britain's Favourite Foods – Are they Good for You?》高清下载
- 美国纪录片《盖瑞·山德林的禅意日记 The Zen Diaries of Garry Shandling》高清下载
- 中国大陆纪录片《东京审判》高清下载
- 英国纪录片《素描的秘密 The Secret of Drawing》高清下载
- 英国纪录片《BBC自然世界 丛林动物医院 Jungle Animal Hospital》高清下载
- 中国香港纪录片《破局之困·俄乌冲突三周年 2025》高清下载
- 美国纪录片《我们在地狱的时光:朝鲜战争 Our Time in Hell: The Korean War》高清下载
- 法国纪录片《禁藥的誘惑 The Race to Dope》高清下载
- 美国纪录片《分裂的美国 The Divided Soul Of America》高清下载
- 法国纪录片《罗马的命运 The Destiny of Rome》高清下载
- 中国大陆纪录片《圆明园》高清下载
- 英国纪录片《女王的宫殿 The Queen's Palaces》高清下载
- 中国大陆纪录片《水脉》高清下载
- 韩国纪录片《朝鲜战争 한국 전쟁》高清下载
- 美国纪录片《越战50年 Vietnam: 50 Years Remembered》高清下载
- 中国大陆纪录片《邂逅》高清下载
- 法国,德国纪录片《好彩 Good Luck》高清下载
- 英国纪录片《贝茨先生与邮局:真实的故事 Mr Bates vs The Post Office: The Real Story》高清下载
- 中国大陆纪录片《但是还有书籍 1-3季》高清下载
- 中国大陆纪录片《大阅兵 2020》高清下载
- 中国大陆纪录片《超级实验室》高清下载
- 美国纪录片《偷窥者 Voyeur》高清下载
- 英国纪录片《厕所秘史 The Toilet: An Unspoken History》高清下载
- 美国纪录片《阿尔特·沃尔夫终极之旅 第一季 Travels to the Edge with Art Wolfe Season 1》高清下载
- 美国纪录片《有史以来卖得最好的电影 The Greatest Movie Ever Sold》高清下载
- 美国纪录片《亚历克斯挑战全美名厨 全2季》高清下载
- 中国台湾纪录片《最美中国 最美中國》高清下载
- 法国纪录片《鸟瞰地球 La Terre vue du ciel》高清下载
- 英国纪录片《与浪争锋 第1-2季全15集 Make or Break Season 1-2》高清下载
- 英国纪录片《地球改变之年 The Year Earth Changed》高清下载
- 中国大陆纪录片《湘西》高清下载
- 英国纪录片《美食通大冒险 Len and Ainsley's Big Food Adventure》高清下载
- 中国大陆纪录片《屈原》高清下载
- 英国纪录片《泛滥澳洲的蔗蟾蜍 Citizen Cane Toad》高清下载
评论 抢沙发
欢迎您留下宝贵的见解!

暂无评论内容